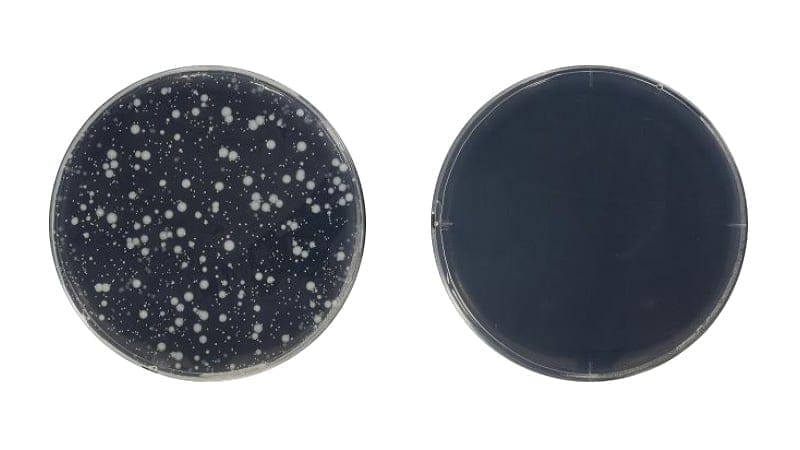

For Those Interested in Infection Control
-
![Numerous invisible bacteria and viruses]()
-
Numerous invisible bacteria and viruses
Touch panel operation terminals such as smart phones have become a necessity in our modern lives, and it is commonplace to touch them anytime, anywhere on a daily basis, but there are countless invisible bacteria and viruses on their operating surfaces.
-
![ウイルスを引き付け固着して離さない。]()
-
Our Lives Under Invisible Threat
While touch panels of various types and sizes are used in various situations, such as train stations, shopping malls, manufacturing plants, and construction sites, they are touched by an unspecified number of people, so it has been required to reduce the risk of infection caused by touch panels.
-
![抗ウイルス剤と活性酸素で抑制させる]()
-
Ever-evolving technology and required tactile manipulation
Although there are new technologies that keep people at a distance and non-contact operation methods that keep people at a distance, machine operation where malfunctions are not tolerated, such as in the medical field and industrial equipment, requires firm touch and input.
Product Information
-
Anti-BacterialInhibition of bacterial growth on the surface of the product
-
SterilizationTo kill or eliminate all microorganisms in the sterilized material
-
InactivationTo kill harmful microorganisms, including pathogens
-
Removing BacteriaTo reduce the number of viable bacteria from an object
-
DisinfectionA treatment used to reduce the number of viable microorganisms, killing only those microorganisms that are harmful to humans or the target microorganisms of interest. It does not necessarily kill or eliminate all microorganisms.
-
![Reducing the number of specific viruses on products]()
-
Reducing the number of specific viruses on products
Having no cell, virus is just a structure and its size is about one thousandth of bacterium. Virus cannot replicate on its own and can be regarded as a matter. Therefore, it is necessary to decompose its structure and reduce its capability to get into a cell in order to inhibit a virus from replication.
-
![It attracts and adheres to the virus and does not let go]()
-
It attracts and adheres to the virus and does not let go
Anti-viral agent (metal) with a positive charge will act on a virus with a negative charge. The virus and anti-viral agent will be attracted by the static electricity level, fixed, and cannot be separated. The antiviral agent will react with the moisture in the air.
-
![Suppressed by antiviral agents and reactive oxygen species]()
-
Suppressed by antiviral agents and reactive oxygen species
The antiviral agent (metal) will react with the moisture in the air to generate active oxygen (OH radical). Because of the high oxidizing power of the active oxygen, it will denature proteins in the viruses. Thus it is expected to reduce number of viruses. * Not all kinds of bacteria and viruses are reduced.
-
![Decorative printable custom films]()
-
Overlay structure type (188μm) is available for customization
Covers and attaches over the resistive touch screen. This makes it possible to embedded Antivirus and Antibacterial resistive touch screen with fully flat state.
Feature of FV SERIES
-
![]()
-
SIAA mark for antibacterial and antiviral certification
FV series is certified by SIAA* (the Society of International sustaining growth for Antimicrobial Articles) for its anti-viral and anti-bacterial functions.
* SIAA mark is displayed on products that are subject to quality control and information disclosure in accordance with the guidelines of the Society of International sustaining growth for Antimicrobial Articles, based on the results of evaluation in accordance with the ISO 21702 /ISO22196 method.
-
![]()
-
Anti-viral Test Result Anti-viral
Activity ValueWater Resistance Virus A
(with envelope)2.1 Water Resistance Virus B
(without envelope)4.0 Light Resistance Virus A
(with envelope)4.1 Light Resistance Virus B
(without envelope)4.0 -
![]()
-
High antiviral functionality per ISO 21702
FV series is effective regardless of whether a virus has envelop or not. The number of viruses decreases by more than 99% in test method conforming to ISO 21702*.
* ISO21702:2019: Measurement of anti-viral activity on plastic and other non-porous surfaces.
-
![]()
-
High antibacterial functionality per ISO 22196
The growth of bacteria shall decrease by more than 99% in the test method conforming to ISO22196*
* ISO22196:2011: Measurement of antibacterial activity on plastics and other non-porous surfaces. -
![]()
-
Anti-bacterial Test Result Anti-bacterial Activity Value Water Resistance Bacteria A >5.8 Water Resistance Bacteria B >4.5 Light Resistance Bacteria A >4.3 Light Resistance Bacteria B >3.6
* About the Film: This anti-viral and anti-bacterial film uses RIKEGUARDR. RIKEGUARDR is a registered trademark of RIKEN TECHNOS.
We can solve these problems
-
![]() I am interested in infection control in industrial settings and would like to use it.
I am interested in infection control in industrial settings and would like to use it.I want to introduce and consider infection control measures for touch panels on on-site devices and equipment.
-
![]() For touch panels in the medical field where cleanliness is always required.
For touch panels in the medical field where cleanliness is always required.To the new common sense that responds to the safety and security of our customers as a measure to prevent infection on a regular basis.
-
![]() For touch panels at public sites that are touched by an unspecified number of people
For touch panels at public sites that are touched by an unspecified number of peopleFor public touch panels used by everyone, such as libraries, government offices, civic centers, daycare centers, etc.
| Test Method 1 | ISO21702 Anti-viral Test | |
|---|---|---|
| Test Method 2 | ISO22196 Anti-bacterial Test | |
| Film Thickness | 167μm | |
| Light Transmittance | Clear : 87%/ Anti-glare : 83% | |
| Anti-viral Activity Value | ≧ 2.0 | |
| Anti-bacterial Activity Value | ≧ 2.0 | |
| Standard Price | Discretionary Price | |
| Size | W x H (mm) | Product NO. | Surface |
|---|---|---|---|
| サイズ | 幅 x 高さ | 製品番号 | 表面処理 | 7w | 153.9 x 92.94 | FV-154093A001 | Clear | 7w | 153.9 x 92.94 | FV-154093B001 | Anti-Glare | 10.4 | 212.7 x 159.9 | FV-213160A001 | Clear | 10.4 | 212.7 x 159.9 | FV-213160B001 | Anti-Glare | 12.1 | 247.5 x 185 | FV-248185A001 | Clear | 12.1 | 247.5 x 185 | FV-248185B001 | Anti-Glare | 15 | 305.63 x 229.6 | FV-306230A001 | Clear | 15 | 305.63 x 229.6 | FV-306230B001 | Anti-Glare | 15.6 | 381.2 x 236.4 | FV-381236A001 | Clear | 15.6 | 381.2 x 236.4 | FV-381236B001 | Anti-Glare |
* The chemicals applied on the films of FV series are subject to Biocidal Products Regulation (BPR). Therefore, the product cannot be exported to Europe.